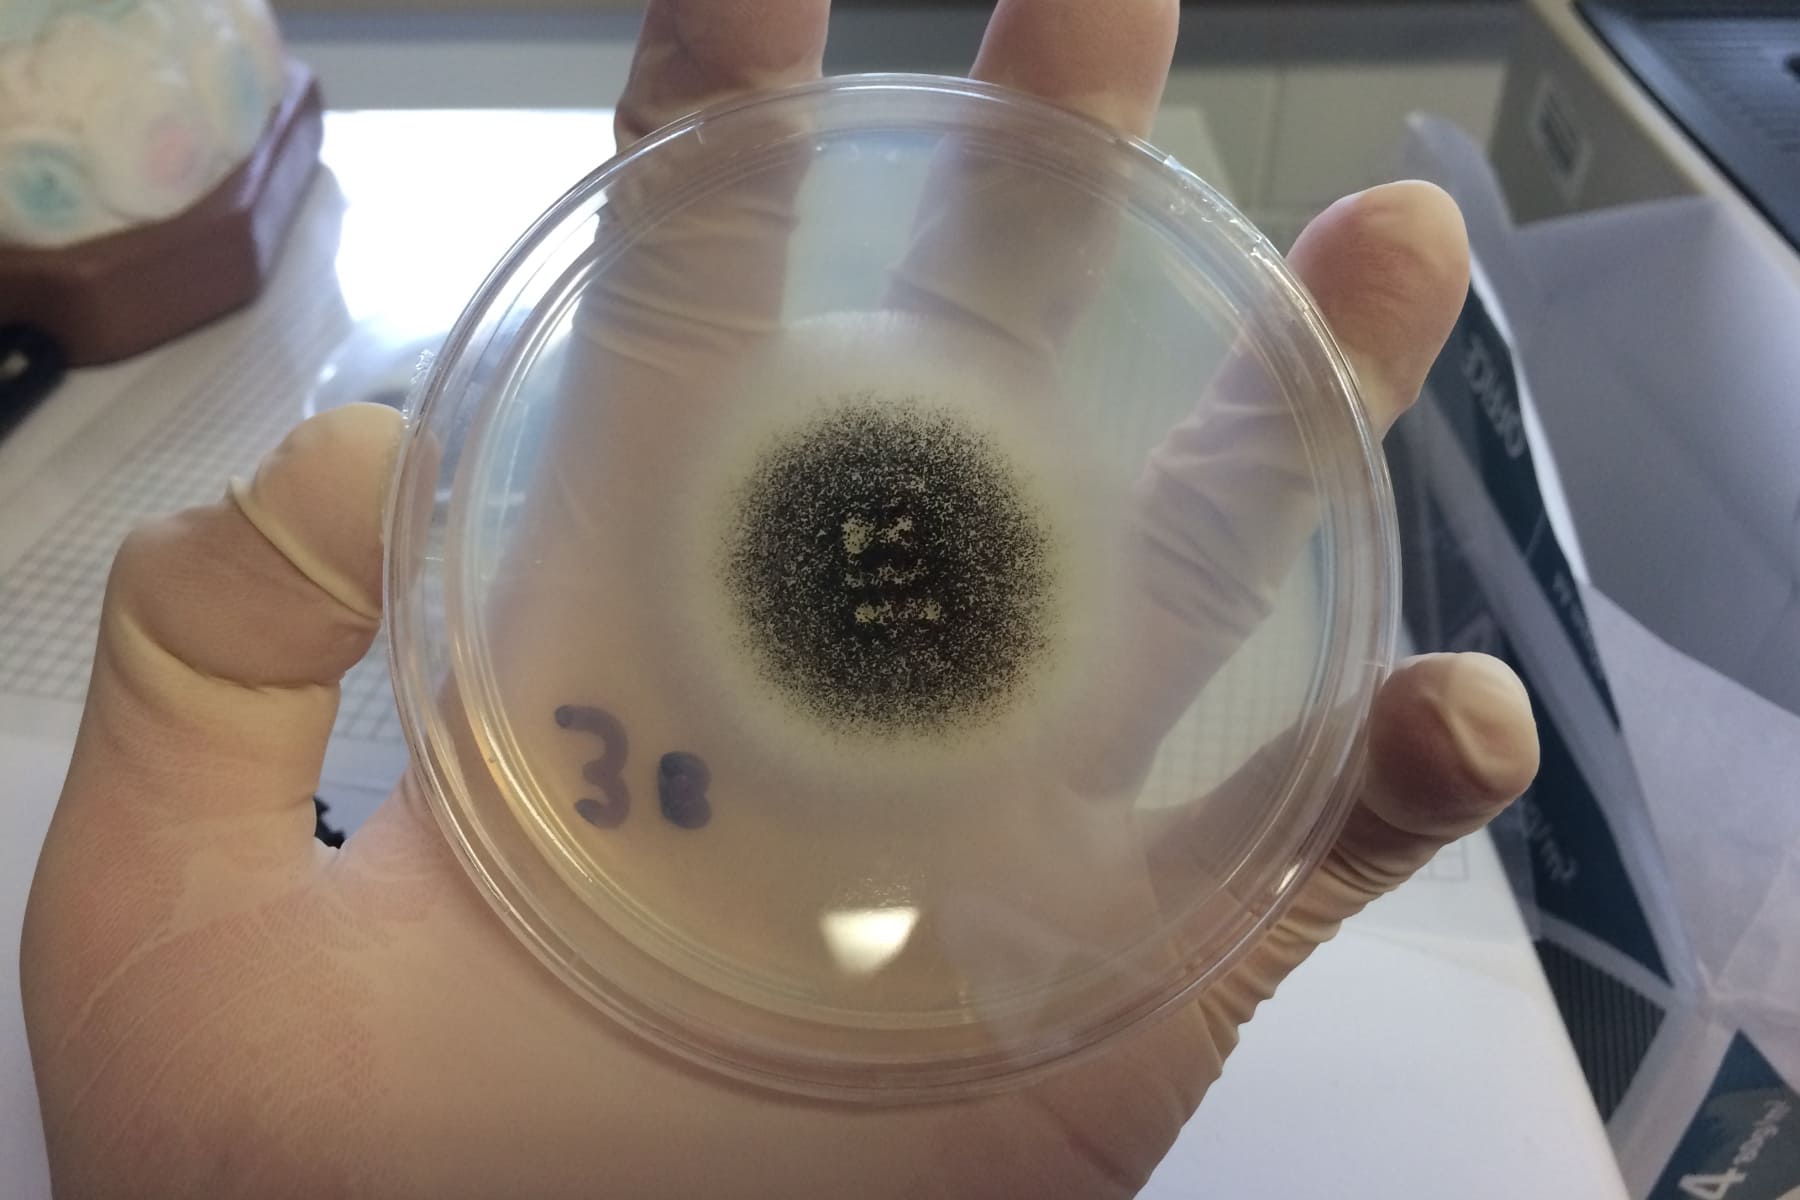

Новые данные показывают, что большинство грибов, выделенных из чистых помещений, являются нитчатыми и, скорее всего, попали в помещение извне.
В статье, опубликованной в Европейском журнале парентеральных и фармацевтических наук (EJPPS), говорится, что наиболее распространенными родами грибов, выделенных в чистых помещениях класса C и D, соответствующих стандарту надлежащей производственной практики (GMP) Европейского союза (ЕС), являются Aspergillus, Candida, Cladosporium, Fusarium и Penicillium.
По словам автора статьи, доктора Тима Сандла (руководителя отдела микробиологии, управления рисками и обеспечения стерильности Bio Products Laboratory), изучение типа, рода и структуры микробиоты в чистых помещениях жизненно важно для микробиологов и специалистов по качеству. Это позволит оценить риски для продукции, предложить мероприятия по устранению последствий, проанализировать изменения в тенденциях и выбрать репрезентативные организмы для исследований по стимулированию роста и эффективности дезинфицирующих средств. Кроме того, он пишет, что изменения в составе этих штаммов могут указывать на появление резистентности, проблем с очисткой или нежелательных микроорганизмов.
Сандл указывает на то, что из различных типов микроорганизмов, которые могут вызвать микробное загрязнение, грибы могут быть наиболее опасными из-за нескольких факторов, включая и то, что они относительно легко рассеиваются и могут расти практически на любом субстрате. Однако, согласно статье, многие причины грибкового заражения на фармацевтических предприятиях связаны с плохим дизайном, стареющими объектами (повреждение материала), плохим контролем поступающих материалов, недостатками систем воздухоподготовки и управления производственными процессами.
Для изучения типов грибов и их потенциальных источников были взяты данные из долгосрочного исследования грибов, выделенных из чистых помещений GMP ЕС класса C и D фармацевтического предприятия, расположенного на юго-востоке Англии.
Ссылаясь на ранее опубликованные работы, автор говорит о том, что большинство микроорганизмов, обнаруженных в чистых помещениях, могут переноситься на кожу человека или обитать на ней. В дополнение к кожной флоре другие типы микроорганизмов будут присутствовать в почве, которая может быть занесена на обуви, одежде или материалах. Наиболее распространенными микроорганизмами в чистых помещениях являются грамположительные бактерии, утверждает Сандл.
Грибы обычно делятся на две различные морфологические формы: дрожжи и гифы (нитчатые грибы). Потенциальная опасность грибкового заражения фармацевтических препаратов заключается в том, что лекарство может испортиться, нарушив свои терапевтические свойства (любой ингредиент рецептуры, от простых сахаров до сложных ароматических молекул, может подвергнуться химической модификации в присутствии подходящего организма), или нанести вред пациенту. Вред может быть нанесен непосредственно грибком или его спорами, а также путем выделения микотоксинов, которые являются продуктами метаболизма нитчатых (мицелиальных) грибов. На сегодняшний день выявлено более 400 различных микотоксинов, и некоторые из основных грибов-продуцентов микотоксинов, связанных с фармацевтическими ингредиентами и условиями хранения или производства, включают Aspergillus, Penicillium и Fusarium.
Некоторые виды исходного сырья могут представлять опасность, если они загрязнены микотоксинами, уточняет автор. Прежде всего, это касается ингредиентов, полученных из целлюлозы или зерна, кизельгура, а также растительного сырья. Кроме того, условия хранения материалов и субстанций (наличие влажности и повышенных температур) представляют собой дополнительный фактор риска.
В материале указывается, что грибы были выделены из образцов, отобранных за десятилетний период (2011 — 2020 годы, см. рисунок), и изоляты, выделенные из среды чистых помещений класса C (ISO 14644 класс 8 в эксплуатации) и класса D, соответствующих стандарту GMP ЕС. Изоляты были взяты из режима мониторинга окружающей среды, разработанного для выявления как бактерий, так и грибов. За весь период исследования было проведено 7 200 идентификаций; 180 из них были грибковыми, 7 020 — бактериальными, а ещё 133 были охарактеризованы на уровне рода или вида.
Было выявлено более 15 родов, наиболее распространенные из них — Aspergillus, Candida, Cladosporium, Fusarium и Penicillium. В целом, 79% были нитчатыми грибами или плесенью. Исходя из того, где обычно встречаются эти микроорганизмы, д-р Сандл предполагает, что 42% из них пришли из внешней среды, 38% — от людей и 20% — из внутренней среды предприятия. Отсюда следует, что большинство этих микроорганизмов переносится в чистое помещение, что может быть минимизировано или предотвращено с помощью соответствующих протоколов.